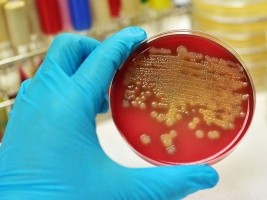
Haiti - Health : Diphtheria kills in Haiti...

|
||||||||||||||||||
| Download the revised decree and electoral calendar, published in the official journal |
|
|
Haiti - Health : Diphtheria kills in Haiti... 24/12/2017 07:28:48
In Haiti, the Diphtheria outbreak began at the end of 2014 and has continued to occur with a total of 348 probable diphtheria cases reported up to 48 epidemiological week (EW) of 2017, including 46 deaths. An increase in cases is observed in the last trimester of 2017 compared to the preceding trimester. Between EW 1 and EW 48 of 2017, 152 probable cases were reported, with a case fatality rate of 10%. Of these cases, 59% are female and 76% are infants under the age of ten. The vaccination history of the probable cases is the following: 11% were vaccinated and 89% did not know or did not have information on their vaccination status. Most of the probable cases (71%) were reported in the departments of Artibonite and Ouest (38% and 33%, respectively); this is similar to what was observed in 2016 with 70% of the cases reported in the same two departments. Of the 152 probable cases reported in 2017, samples were taken from 141 cases, of which 64 (45%) were laboratory confirmed, 52 were discarded, and 25 remain under investigation. Of the confirmed cases, 81% (52) are from the departments of Artibonite and Ouest. Let's recall that according to the Haiti Ministry of Public Health and Population, a probable case is defined as a person, regardless of age, with laryngitis, pharyngitis, or tonsillitis with adherent pseudomembranes on tonsils, pharynx, and/or nostrils in conjunction with neck edema. Epidemiological surveillance is being intensified to detect the population at risk and to implement public health measures, including a vaccination campaign expected to take place in 2018. HL/ HaitiLibre
|
|
|
Why HaitiLibre ? |
Contact us |
Français
Copyright © 2010 - 2026 Haitilibre.com |